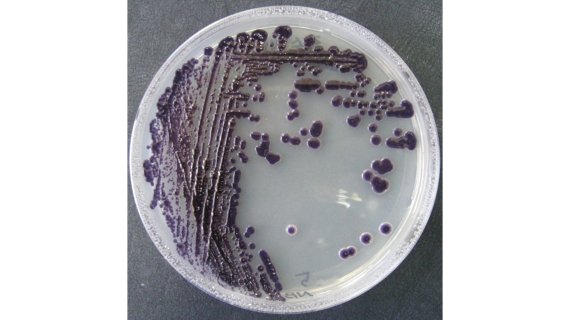

(부산=뉴스1) 백창훈 기자 = 국립수산과학원은 스쿠티카충 억제 물질인 비올라세인(violacein)을 생산하는 신종 미생물 '마실리아균주'를 발견했다고 16일 밝혔다.
스쿠티카충은 스쿠티카병을 유발하는 기생충이다. 주로 넙치의 대량 폐사를 일으키며, 치어기에 많이 감염되는 것으로 알려졌다.
수산과학원은 항균활성을 가진 미생물들을 넙치 양식장에서 확보·분리 후 그 중에서 비올라세인 물질을 생산하는 신종 미생물인 마실리아균주를 발견했다.
이 균주의 유전체가 625만개의 염기쌍으로 이뤄진 것을 해독했으며, 각 유전자의 정보를 통해 비올라세인 생산 과정도 밝혀냈다.
이 균주는 스쿠티카충을 억제시키는 활성이 우수할 뿐만 아니라 다양한 어류 질병을 일으키는 세균과 식중독균 등에 대한 항균활성도 높은 것으로 나타났다.
비올라세인은 스쿠티카충의 구제재 역할은 물론 친환경 수산용 의약소재로서의 활용 가능성도 확인되면서 식품, 화장품, 의약품 등 다양한 산업분야에도 활용될 것으로 보인다.
※ 저작권자 ⓒ 뉴스1코리아, 무단전재-재배포 금지